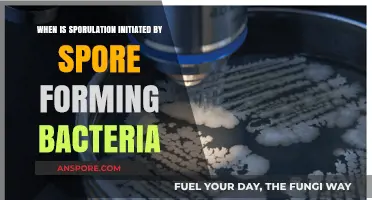
Sporulation Timing: How and When Spore-Forming Bacteria Initiate the Process

*Spore*, the evolutionary life simulation game developed by Maxis and designed by Will Wright, offers players a unique journey from microscopic life to galactic exploration. While the game was originally released for PC and Mac in 2008, it has since become accessible on various platforms, including modern operating systems like Windows 10 and macOS. Players can purchase and download *Spore* through digital distribution platforms such as Steam, Origin, and GOG, ensuring compatibility with current hardware. Additionally, the game’s standalone expansion, *Spore Galactic Adventures*, and other add-ons can enhance the experience. For those seeking a nostalgic or budget-friendly option, physical copies of the game are still available on sites like eBay or Amazon. Whether you’re revisiting this classic or discovering it for the first time, *Spore* remains a captivating experience across multiple platforms.
| Characteristics | Values |
|---|---|
| Platform | PC (Windows), Mac, Linux (via compatibility layers like Wine) |
| Digital Stores | Steam, GOG.com, Origin (EA App), Physical Disc (out of print) |
| System Requirements | Windows: XP/Vista/7, Mac: OS X 10.5.8 or later, Linux: Varies by setup |
| Game Version | Spore (Base Game), Spore Galactic Edition (includes expansions) |
| Multiplayer | No active online multiplayer; Sporepedia for sharing creations |
| Mod Support | Yes, via third-party mods and tools |
| Controller Support | Limited; primarily designed for keyboard and mouse |
| Price Range | $9.99 - $19.99 (varies by store and edition) |
| Availability | Digital only (physical copies rare and not officially sold) |
| Latest Update | Patch 5.1 (released in 2009; no recent updates) |
| Compatibility | May require tweaks for modern systems (e.g., Windows 10/11) |
| Community | Active modding and creation-sharing communities on Reddit, forums, etc. |
Explore related products
What You'll Learn
- PC Requirements: Check system specs for optimal gameplay on Windows or Mac computers
- Mobile Platforms: Play Spore on iOS or Android devices with adapted controls
- Console Versions: Enjoy Spore on PlayStation or Xbox for a living room experience
- Online Emulators: Access Spore via browser-based emulators for quick, no-download play
- Cloud Gaming: Stream Spore on services like GeForce Now or Stadia

PC Requirements: Check system specs for optimal gameplay on Windows or Mac computers
Before diving into the world of *Spore*, ensure your computer meets the necessary system requirements to avoid frustrating lags or crashes. For Windows users, the game demands a modest setup: a 2.0 GHz CPU, 512 MB RAM, and a 128 MB video card with Shader Model 2.0 support. Mac players need slightly beefier specs, including a 2.0 GHz Intel Core 2 Duo processor, 2 GB RAM, and a 128 MB video card. These baseline specs guarantee smooth gameplay, but upgrading to a 3.0 GHz CPU, 1 GB RAM, and a 256 MB video card will enhance your experience, especially when managing complex ecosystems or large-scale creations.
Analyzing the requirements reveals a key difference between Windows and Mac setups: Mac users need double the RAM to run *Spore* effectively. This disparity highlights the importance of checking your system’s specs before installation. For older machines, consider upgrading RAM or freeing up disk space to meet these demands. Additionally, ensure your operating system is up-to-date, as *Spore* requires at least Windows XP SP2 or Mac OS X 10.5.7. Compatibility issues can arise from outdated software, so a quick system check can save hours of troubleshooting later.
Persuasively, investing in a machine that exceeds these requirements isn’t just about future-proofing—it’s about unlocking *Spore*’s full potential. Higher-end GPUs, like those with Shader Model 3.0 support, enable better graphics rendering, making your creatures and worlds more visually stunning. Similarly, a faster CPU ensures seamless transitions between the game’s five stages, from microscopic origins to galactic exploration. While *Spore* isn’t graphically intensive by modern standards, a robust system enhances immersion and creativity, allowing you to focus on evolving your species rather than battling technical limitations.
Comparatively, *Spore*’s system requirements are far less demanding than those of contemporary AAA titles, making it accessible to a wide range of players. However, this accessibility doesn’t mean you should skimp on hardware. For instance, while a 128 MB video card is sufficient, a 512 MB or higher card will significantly improve performance, especially during later stages of the game where complexity increases. Similarly, opting for a solid-state drive (SSD) over a traditional hard drive reduces loading times, ensuring a smoother experience as you jump between planets and civilizations.
Descriptively, imagine this scenario: you’ve spent hours crafting the perfect creature, only to have the game stutter or freeze during a critical evolution phase. Such disruptions can ruin the immersive experience *Spore* offers. By verifying your system specs beforehand, you safeguard against these issues. Tools like Can You Run It or System Requirements Lab can automatically assess your computer’s compatibility, providing a clear yes or no answer. If your machine falls short, consider playing *Spore* on a gaming laptop or via cloud gaming services like NVIDIA GeForce Now, which stream the game to your device without taxing local hardware. This way, you can enjoy *Spore*’s boundless creativity without being tethered to high-end specs.
C. Diff Spores Survival: How Long Do They Live on Surfaces?
You may want to see also

Mobile Platforms: Play Spore on iOS or Android devices with adapted controls
For those who crave the evolutionary sandbox of Spore on the go, mobile platforms offer a tantalizing possibility. While an official mobile port of the full Spore experience remains elusive, adapted versions and inspired alternatives bring the essence of the game to iOS and Android devices. These adaptations focus on streamlining the complex controls and interfaces of the original PC version for touchscreen interaction, often emphasizing specific stages of the game.
Imagine guiding your creature through the tactile world of the Cell Stage, using intuitive swipe gestures to navigate and devour. Think of the Creature Stage as a finger-painting exercise in evolution, shaping your organism with taps and drags. These mobile interpretations prioritize accessibility and bite-sized gameplay sessions, perfect for commuting or quick bursts of creative exploration.
Key Considerations:
- Control Schemes: Look for adaptations that utilize intuitive touch controls, avoiding cluttered interfaces that hinder the experience. Virtual joysticks and contextual buttons can work well, but innovative solutions like tilt controls for creature movement could offer a unique twist.
- Gameplay Focus: Mobile versions often condense the full Spore experience, focusing on specific stages. Decide which aspect of the game appeals most to you: the primal survival of the Cell Stage, the creative freedom of the Creature Stage, or perhaps a simplified version of the later space exploration.
- Performance: Consider your device's capabilities. While optimized for mobile, complex graphics and simulations can still tax older hardware.
Exploring Options:
While an official Spore mobile port is absent, several titles capture the spirit of the game:
- Spore Origins: This early mobile game focused solely on the Cell Stage, offering a simplified but engaging experience.
- Spore Creatures: Designed for Nintendo DS, this title emphasized creature creation and social interaction, showcasing the potential for a more narrative-driven mobile Spore experience.
- Indie Alternatives: Keep an eye out for indie developers creating Spore-inspired games for mobile. These often experiment with unique mechanics and art styles, offering fresh takes on the evolutionary theme.
The Future of Spore on Mobile:
The demand for a full Spore experience on mobile is undeniable. With advancements in mobile hardware and the success of complex strategy games on smartphones, a faithful adaptation seems increasingly feasible. Imagine a version that leverages cloud saves, allowing seamless progression across devices, or incorporates social features for collaborative evolution.
Best Places to Purchase Morel Mushroom Spores for Cultivation
You may want to see also

Console Versions: Enjoy Spore on PlayStation or Xbox for a living room experience
For those who prefer the comfort of their living room and the tactile feedback of a controller, Spore offers a unique experience on PlayStation and Xbox consoles. Unlike the PC version, which relies heavily on mouse and keyboard precision, the console versions are optimized for gamepad controls, making it accessible to a broader audience. This adaptation ensures that players can seamlessly navigate the game’s five evolutionary stages—from Cell to Space—without the learning curve of complex keyboard shortcuts. Whether you’re crafting creatures in the Creature Creator or exploring galaxies, the console interface streamlines the process, allowing you to focus on creativity and exploration.
One of the standout features of Spore on consoles is the social aspect it brings to the living room. Multiplayer modes, such as the "Space Stage" cooperative play, allow friends and family to join in on the adventure. Imagine collaborating to terraform planets or competing to build the most impressive spacecraft, all from the comfort of your couch. This shared experience enhances the game’s replayability and makes it a great choice for group gaming sessions. Additionally, the console versions often include exclusive content, such as additional creature parts or missions, providing fresh challenges for both new and returning players.
However, it’s important to note that the console versions of Spore have some limitations compared to the PC edition. The modding community, which has significantly extended the PC version’s lifespan, is largely absent on consoles. This means you won’t find the same level of user-generated content or customization options. Additionally, the graphics and performance may not match the high-end capabilities of modern PCs, though they are still visually appealing and run smoothly on supported systems. For players who prioritize accessibility and shared experiences over technical superiority, these trade-offs are often well worth it.
To get started, ensure your console is compatible with the Spore version you’re interested in. The game is available on PlayStation 3 and Xbox 360, with backward compatibility on newer systems like the Xbox One and Series X/S. If you’re purchasing a physical copy, check for any installation requirements, as some versions may need additional downloads. For families, consider setting up profiles for each player to track individual progress and creations. Finally, take advantage of the console’s save system to experiment freely—whether you’re evolving a carnivorous creature or building a utopian civilization, the living room setup encourages creativity without the pressure of perfection.
Does Milky Spore Kill All Grubs? A Comprehensive Guide
You may want to see also
Explore related products

Online Emulators: Access Spore via browser-based emulators for quick, no-download play
Browser-based emulators offer a seamless way to play *Spore* without the hassle of downloads or installations. These platforms simulate the game’s original environment directly in your web browser, making it accessible on virtually any device with an internet connection. Popular options like Archive.org’s Internet Archive or dedicated gaming emulator sites often host *Spore* alongside other classic titles. This method is ideal for players seeking instant gratification or those with limited storage space.
To get started, simply search for a reputable emulator site hosting *Spore*. Once on the platform, click the play button, and the game will load within seconds, depending on your internet speed. Most emulators require no account creation or additional software, though some may prompt you to enable Flash or other plugins if your browser doesn’t support them natively. Keep in mind that while these emulators are convenient, they may lack the full functionality of a downloaded version, such as save-file persistence or advanced graphics settings.
One of the standout advantages of browser-based emulators is their cross-platform compatibility. Whether you’re on a Windows PC, Mac, Chromebook, or even a Linux machine, you can dive into *Spore* without worrying about system requirements. This accessibility extends to mobile devices as well, though touchscreen controls may feel less intuitive than a keyboard and mouse. For the best experience, use a device with a larger screen and a stable internet connection to minimize lag.
However, there are a few caveats to consider. Browser-based emulators rely on server performance, so gameplay may stutter during peak hours or if the site experiences high traffic. Additionally, while most platforms are free, some may display ads or require you to watch a short video before playing. To avoid potential issues, bookmark a trusted emulator site and clear your browser cache periodically to ensure smooth performance.
In conclusion, online emulators provide a quick, no-fuss way to enjoy *Spore* across devices. While they may not replace a full installation, they’re perfect for casual play or revisiting the game without commitment. With a few clicks, you can relive the evolution of your creatures, from microscopic organisms to interstellar explorers, all from the comfort of your browser.
Understanding Mold Spore Size: Invisible Threats and Their Impact
You may want to see also

Cloud Gaming: Stream Spore on services like GeForce Now or Stadia
Cloud gaming has revolutionized how we access and play older titles like *Spore*, eliminating the need for high-end hardware. Services like GeForce Now and Stadia allow you to stream *Spore* directly to your device, whether it’s a laptop, tablet, or even a smartphone. This means you can revisit Maxis’s evolutionary masterpiece without worrying about compatibility issues or outdated system requirements. Simply log in, search for *Spore*, and start playing—no downloads or installations required.
To get started, ensure your internet connection meets the minimum requirements: 15 Mbps for 720p at 60 FPS or 35 Mbps for 1080p at 60 FPS. Both GeForce Now and Stadia recommend a stable connection to avoid lag, which can disrupt the seamless experience *Spore* demands, especially during fast-paced space exploration or creature editing. If you’re using Wi-Fi, position your router close to your device or use an Ethernet connection for optimal performance.
GeForce Now stands out for its compatibility with games you already own on platforms like Steam. If you have *Spore* in your Steam library, you can link your account and stream it instantly. Stadia, on the other hand, requires purchasing the game through its platform, but it offers a free tier with limited features, making it a budget-friendly option for casual players. Both services support controllers, so dust off your Xbox or PlayStation controller for a more immersive experience.
One caution: cloud gaming relies heavily on server performance. During peak hours, you might experience latency or reduced visual quality. To mitigate this, play during off-peak times or subscribe to premium tiers like GeForce Now Priority or Stadia Pro, which offer priority access and higher resolutions. Additionally, keep your device’s software updated to ensure compatibility with the streaming client.
In conclusion, cloud gaming services like GeForce Now and Stadia offer a hassle-free way to play *Spore* on virtually any device. With minimal setup and no need for powerful hardware, they’re ideal for both nostalgia seekers and new players. Just remember to check your internet speed, choose the right service based on your game library, and consider premium options for the best experience. Whether you’re crafting creatures or colonizing galaxies, cloud gaming ensures *Spore* remains accessible for years to come.
Breloom's Spore Move: Learning Level and Battle Strategy Guide
You may want to see also
Frequently asked questions
Spore can be played on PC (Windows and Mac) via platforms like Steam, Origin, or GOG.
No, Spore is not available on PlayStation or Xbox; it is exclusively a PC game.
No, Spore is not officially available for mobile devices, though there are spin-off mobile games like *Spore Origins* and *Spore Creatures*.
Yes, Spore is compatible with modern Windows operating systems, though some users may need to adjust settings for optimal performance.
Spore is primarily a single-player game, but you can share creations with others through the Sporepedia online community.